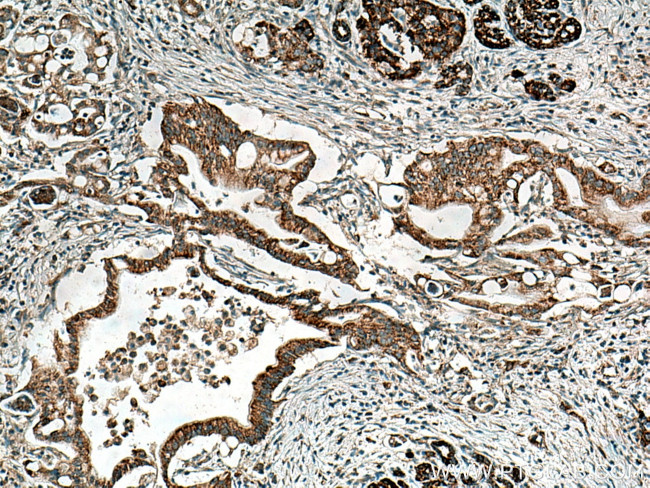
MAOA Antibody in Immunohistochemistry (Paraffin) (IHC (P))
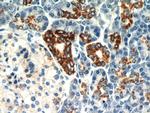
MAOA Antibody in Immunohistochemistry (Paraffin) (IHC (P))

Search
Proteintech
MAOA Polyclonal Antibody
{{$productOrderCtrl.translations['antibody.pdp.commerceCard.promotion.promotions']}}
{{$productOrderCtrl.translations['antibody.pdp.commerceCard.promotion.viewpromo']}}
{{$productOrderCtrl.translations['antibody.pdp.commerceCard.promotion.promocode']}}: {{promo.promoCode}} {{promo.promoTitle}} {{promo.promoDescription}}. {{$productOrderCtrl.translations['antibody.pdp.commerceCard.promotion.learnmore']}}
产品信息
10539-1-AP
种属反应
已发表种属
宿主/亚型
分类
类型
抗原
偶联物
形式
浓度
规格
纯化类型
保存液
内含物
保存条件
运输条件
产品详细信息
Immunogen sequence: HPVTHVDQS SDNIIIETLN HEHYECKYVI NAIPPTLTAK IHFRPELPAE RNQLIQRLPM GAVIKCMMYY KEAFWKKKDY CGCMIIEDED APISITLDDT KPDGSLPAIM GFILARKADR LAKLHKEIRK KKICELYAKV LGSQEALHPV HYEEKNWCEE QYSGGCYTAY FPPGIMTQYG RVIRQPVGRI FFAGTETATK WSGYMEGAVE AGERAAREVL NGLGKVTEKD IWVQEPESKD VPAVEITHTF WERNLPSVSG LLKIIGFSTS VTALGFVLYK YKLLPRS (242-527 aa encoded by BC008064 )
靶标信息
This gene encodes monoamine oxidase A, an enzyme that degrades amine neurotransmitters, such as dopamine, norepinephrine, and serotonin. The protein localizes to the mitochondrial outer membrane. The gene is adjacent to a related gene on the opposite strand of chromosome X. Mutation in this gene results in monoamine oxidase deficiency, or Brunner syndrome.
仅用于科研。不用于诊断过程。未经明确授权不得转售。
生物信息学
蛋白别名: Amine oxidase [flavin-containing] A; HGNC:6833; MAO-A; Monoamine oxidase type A; RP1-201D17__B.2; unnamed protein product
基因别名: BRNRS; MAO-A; MAOA
UniProt ID: (Human) P21397
Entrez Gene ID: (Human) 4128